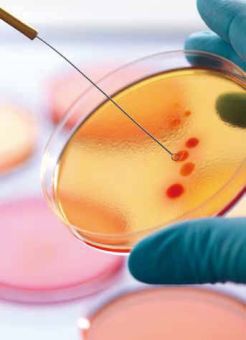
病理诊断是诊断肿瘤的“金标准

|
病理诊断是诊断肿瘤的“金标准”,其他检查都只是有助于医生发现、判断病情,或在治疗过程中跟踪效果。 教你看懂肺癌病理报告 对于肺癌患者而言,疾病诊断最终要依靠支气管镜或手术切除以后,获取的标本进行病理检测来判断。病理诊断是诊断肿瘤的“金标准”,其他检查都只是有助于医生发现、判断病情,或在治疗过程中跟踪治疗效果。也就是说,其他任何检查,如CT、MRI等,即使在影像上发现有肿块、病灶,都不能最终判断病变的性质、类型,确诊还要依靠病理诊断。这是肿瘤治疗过程中,十分关键的依据。 什么是大病理和小病理? 一般来说,病理诊断中的大病理是指手术切除后获取的标本进行的病理检测,小病理则是指通过支气管镜、腔镜、胃镜或穿刺获取的活检标本进行的病理检测。此外,在人体的体表进行活检取材获取的标本进行的病理检测也称为小病理。 一个完整的病理诊断包括哪些信息? 通常,一个完整的病理诊断包括四个方面的信息: (1)病人的基本信息:如姓名、性别、年龄以及病理号。其中,病理号是每个病人在检查的医院里拥有的唯一号码,十分重要。此外,每家医院根据情况不同,基本信息中还有病人的病案号或ID号等。 (2)报告的内容:即送检标本来源的方式和部位。也就是说,需要标明标本来源于哪个器官,通过哪种方式获取的,如穿刺、腔镜或手术切除等。 (3)病理报告的内容:病理报告内容是整个病理诊断中最重要的部分,包含通过检测后发现的病变类型、性质。手术切除获取的标本还包含肿瘤侵犯的范围、淋巴结是否发生转移以及有无脉管瘤栓等。此外,如果肿瘤病变不典型,在病理报告内容中还需增添鉴别诊断的内容,而肿瘤的鉴别诊断常常运用免疫组化的方法来实现。 (4)分子分型:对于肺癌来说,分子分型也是病理诊断报告中很重要的一部分。但分子分型报告的具体内容,有可能是后续单独发报告,也有可能就在病理报告中附上,形成第四部分。 病理报告上的那些术语,都代表什么? 肺癌分为很多种亚型,腺癌、鳞癌、小细胞癌、大细胞癌等都是常见的类型。而不同类型的肺癌,治疗方式是不一样的。此外,肺癌的不同类型还会影响到分子检测的策略、途径。
首先说免疫组化,即免疫组织化学检测,是病理诊断中一种常用的检测手段。即对送检的标本,无论是小标本还是大标本,进行切片、染色,进而根据化学反应使标记抗体的显色剂显色,以此来确定组织细胞内的抗原,对其进行定位、定性及定量的研究。免疫组化对于病理诊断中肿瘤的鉴别诊断、肺癌类型的判断,甚至对肺癌后续治疗都是十分有帮助的。此外,免疫组化可用于肺癌分子分型的判断,即运用免疫组化的方法进行基因检测。 “+”或者“-”代表什么? “+”就是指免疫组化中染色为阳性,即有基因突变,反之,“-”就是指染色为阴性,没有基因突变。“+”“-”在鉴别诊断当中都有临床意义,并不能说“+”就是好,“-”就是不好。 免疫组化结果中,常常出现的EGFR、ALK是什么意思? EGFR、ALK是肺癌中常见的两个分子类型,目前全世界都推荐肺癌患者一定要去检测这两个基因,因为一旦检测出基因突变阳性,患者将有疗效不错的靶向药物可以使用。所以,如果有必要做分子病理检测,这两个基因都要常规检测。EGFR、ALK的基因检测均有明确的指南和专家共识推荐。 《中国EGFR与ALK阳性NSCLC诊断及治疗指南》推荐,所有腺癌或含有腺癌成分的肺癌,原则上都需要做EGFR和ALK基因检测。此外,以前并不推荐鳞癌做基因检测,但现在新的一版指南中指出,获取的小标本中由于鳞癌可能会混杂部分腺癌,因此,使用小标本进行病理检测诊断为鳞癌的患者,如果是不吸烟的年轻女性,其他基因检测为阴性时,建议做ALK基因检测。 不能手术的肺癌患者也能进行基因检测吗? EGFR是肺癌中常见的一种突变基因,在这个基因上有很多片段,每个片段的异常对临床用药都可能有一定指导意义。EGFR中大部分的基因片段属于敏感性突变,部分属于非敏感性突变。而EGFR-E746、EGFR-L858都是EGFR基因检测中,针对一些片段所检测的位点,当EGFR-E746、EGFR-L858出现“+”时,说明有基因突变,如果出现“-”时,说明没有基因突变。除了这两个检测位点外,还需要检测其他位点,查看检测位点对应的基因片段是否出现突变。当检测出某些片段存在基因突变时,患者一定要及时咨询临床医师或者病理医师,该片段基因突变阳性是否适合使用靶向药物,医生都会给出专业的建议。
目前中国的专家共识中,推荐免疫组织化学(IHC)、聚合酶链反应(PCR)以及荧光原位杂交(FISH)等方法检测ALK基因。只要推荐的方法中有任何一种方法检测出ALK为阳性,都表示患者需要进行靶向治疗。在检测方法中,有一种比较常用的免疫组化方法为Ventana IHC。通过Ventana IHC检测出ALK为阳性时,可以直接进行后续的靶向治疗,不用做其他分子检测。 文章来源于《抗癌之窗》 (责任编辑:康复乐园) |